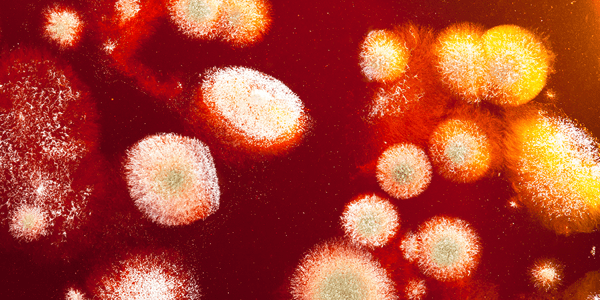

매거진 퍼즐
손톱에도 무좀이 생긴다고?
“젤 네일 제거했더니 손톱이 거뭇해져있네? ”
“온 가족에게 곰팡이를 옮긴 범인은 바로 당신”
양말 냄새를 맡다가 곰팡이 균이 폐에 감염된 한 중국 남성의 사연을 들어본 적 있으신가요?
중국 푸젠성의 장저우시에 사는 “펑”이라는 남성은 어느 날 갑자기 심한 가슴 통증과 함께 기침을 호소하며 인근 병원을 찾아갑니다. 폐렴 증상을 보인다고 생각한 의료진들은 치료를 진행하지만, 몇 주가 지나도록 펑의 증세는 좋아지지 않습니다. 정밀 검사를 통해 펑의 폐에 곰팡이가 감염됐다는 사실을 알아낸 의료진은 펑에게 추가 질문을 하는데요, 이때 펑은 조심스럽게 자신의 취미를 이야기합니다.
“사실 매일 밤마다 집에서 쉬면서 땀이 찬 내 양말 냄새를 맡는 게 취미였습니다.”라고…
이야기를 들은 의료진은 경악을 금치 못하였고, 결국 펑에게 나타난 증상은 양말에 있던 곰팡이균이 냄새를 맡는 과정에서 코로 들어가 폐로 감염되어 폐진균증에 걸린 것으로 추정하였습니다. 이러한 곰팡이 균은 심각하면 목숨을 위협할 수 있으므로 평소 관리 및 주의가 필요합니다.
곰팡이! 정말 끈질기네
우리 주변에서 쉽게 접할 수 있는 곰팡이균은 바로 손과 발에 생기는 무좀입니다. 무좀은 표재성 곰팡이 질환으로 부르기도 하는데, 즉 곰팡이균에 의한 질환이라는 것을 알 수 있습니다. 흔히 무좀은 발에 생긴다고 알고 있지만 손톱과 손바닥에도 무좀이 생길 수 있습니다.
무좀이 생기는 이유는 무좀이 있는 사람과 피부 접촉을 한다거나 수영장, 목욕탕 등에서 공동 시설을 함께 사용하면서 감염되기도 합니다. 또한 발이나 손에 습도가 높은 환경이 유지되거나 당뇨병이나 만성 질환이 있는 경우 걸어 다니다가 피부에 손상이 생긴 틈을 통해 감염이 될 수도 있습니다. 이전에는 주로 중장년층 남성에게서 많이 발병한 무좀이 최근 젤 네일, 젤 페디큐어 등으로 인해 젊은 여성층 사이에서 늘고 있으며, 특히 여름에는 습도가 높아 곰팡이균의 번식 위험이 높기에 주의가 필요합니다.
피가 나게 긁어서 아픈데 또 가렵다
무좀은 흔히 성인 남성에게서 많이 발생하는데요, 무좀이 생기면 피부가 짓무르고 습기에 불어서 하얗게 되거나 갈라져 각질이 벗겨집니다. 만약 땀이 많이 날 경우, 불쾌한 냄새를 동반하기도 하고 가려움증을 호소할 수 있습니다. 반면 가려움증 없이 각질이 전체적으로 두꺼워져 고운 가루처럼 떨어지는 경우도 있습니다.
일반적으로 무좀을 예방하기 위해서는 손과 발의 청결 유지가 가장 중요하고, 신발을 신을 때도 주의가 필요합니다. 또한 젤 네일 등을 한 경우 물놀이 후 당일 제거하는 것이 바람직합니다.

[참고 자료]
1. 서울대학교병원 의학정보 (http://www.snuh.org)
2. 질병관리청 국가건강정보포털 (https://health.kdca.go.kr)
3. Macit llkit, Murat Durdu, Tinea pedis: the etiology and global epidemiology of a common fungal infection, Crut Rev Microbiol, 41(3):374-88, 2015.
마이퍼즐은 당신의 라이프스타일, 생활습관을 꼼꼼하게 분석하여 개인에게 꼭 필요한 건강기능식품을 추천합니다
글 마이퍼즐 학술팀
* 본 컨텐츠의 저작권은 (주)뉴트리원에게 있습니다.



